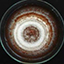

-
107
-
29
-
26
-
23
-
22
Search
Search Results
##search.searchResults.foundPlural##
-
New in vitro dna polymerase activity and fidelity assay reveals age-dependent changes in Arabidopsis Thaliana
1705PDF: 498HTML: 81Supplementary Figure 1: 152Supplementary Figure 2: 140Supplementary Figure 3: 129Supplementary Figure 4: 133Supplementary Figure 5: 138Supplementary Figure 6: 142Supplementary Figure 7: 153Supplementary Figure 8: 132Supplementary Figure 9: 130 -
Kinetics study the decomposition of the cellulose into cellulose nanocrystals by hydrothermal with hydrochloric acid catalyst
1073PDF: 552Supplementary Tables: 207HTML: 131 -
Seed extracts impede germination in Brassica rapa plants
5024PDF: 640HTML: 244